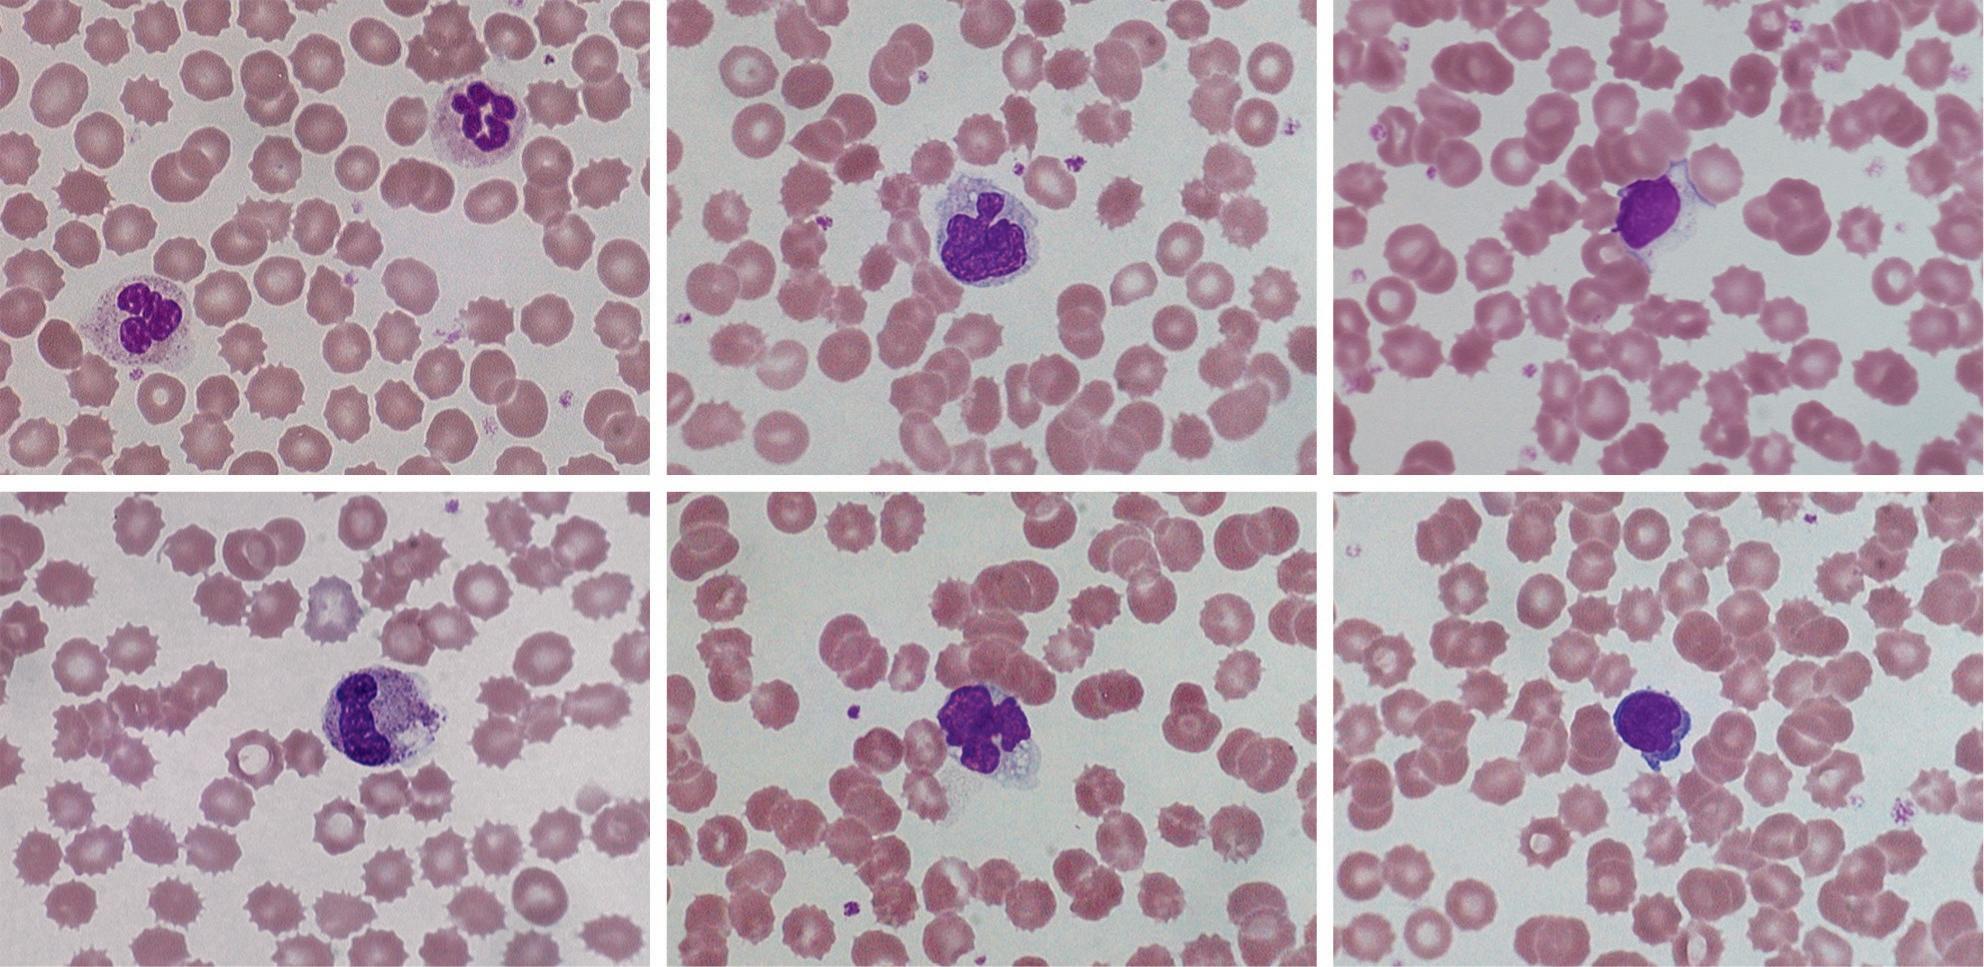

https://ebookmass.com/product/dacie-and-lewis-practicalhaematology-12th-edition-barbara-j-bain/
Instant digital products (PDF, ePub, MOBI) ready for you
Download now and discover formats that fit your needs...
Dacie and Lewis Practical Haematology 12th 12th Edition
Barbara J. Bain
https://ebookmass.com/product/dacie-and-lewis-practicalhaematology-12th-12th-edition-barbara-j-bain/
ebookmass.com
Dacie and Lewis Collins Prcctical Haematology 12TH Edition
Barbara J. Bain
https://ebookmass.com/product/dacie-and-lewis-collins-prccticalhaematology-12th-edition-barbara-j-bain/
ebookmass.com
Practical Flow Cytometry in Haematology: 100 Worked Examples 1st Edition u2013 Ebook PDF Version
https://ebookmass.com/product/practical-flow-cytometry-inhaematology-100-worked-examples-1st-edition-ebook-pdf-version/ ebookmass.com
CAIN (Blood Angel Chronicles Book 5) Jennifer Field
https://ebookmass.com/product/cain-blood-angel-chroniclesbook-5-jennifer-field/
ebookmass.com
© 2017, Elsevier Limited. All rights reserved.
First edition 1950
Second edition 1956
Third edition 1963
Fourth edition 1968
Fifth edition 1975
Sixth edition 1984
Seventh edition 1991
Eighth edition 1995
Ninth edition 2001
Tenth edition 2006
Eleventh edition 2012
Twelfth edition 2017
Preface figure of John V. Dacie, with permission from Lewis M; Sir John Dacie MD, FRS, FRCP, FRCPath, Br J Haematol. 2005 Sep;130(6):834-44.
The right of Barbara J. Bain, Imelda Bates, Michael A. Laffan and S. Mitchell Lewis, to be identified as authors of this work has been asserted by them in accordance with the Copyright, Designs and Patents Act 1988.
No part of this publication may be reproduced or transmitted in any form or by any means, electronic or mechanical, including photocopying, recording, or any information storage and retrieval system, without permission in writing from the publisher. Details on how to seek permission, further information about the Publisher’s permissions policies and our arrangements with organizations such as the Copyright Clearance Center and the Copyright Licensing Agency, can be found at our website: www.elsevier.com/permissions.
This book and the individual contributions contained in it are protected under copyright by the Publisher (other than as may be noted herein).
Notices
Knowledge and best practice in this field are constantly changing. As new research and experience broaden our understanding, changes in research methods, professional practices or medical treatment may become necessary.
Practitioners and researchers must always rely on their own experience and knowledge in evaluating and using any information, methods, compounds or experiments described herein. In using such information or methods they should be mindful of their own safety and the safety of others, including parties for whom they have a professional responsibility.
With respect to any drug or pharmaceutical products identified, readers are advised to check the most current information provided (i) on procedures featured or (ii) by the manufacturer of each product to be administered, to verify the recommended dose or formula, the method and duration of administration and contraindications. It is the responsibility of practitioners, relying on their own experience and knowledge of their patients, to make diagnoses, to determine dosages and the best treatment for each individual patient and to take all appropriate safety precautions.
To the fullest extent of the law, neither the Publisher nor the authors, contributors, or editors, assume any liability for any injury and/or damage to persons or property as a matter of products liability, negligence or otherwise, or from any use or operation of any methods, products, instructions, or ideas contained in the material herein.
ISBN: 978-0-7020-6696-2
International ISBN: 978-0-7020-6930-7
eBook ISBN: 978-0-7020-6935-3
Printed in China
Last digit is the print number: 9 8 7 6 5 4 3 2 1
Senior Content Strategist: Suzanne Toppy
Content Development Specialist: Humayra Rahman Khan
Project Manager: Joanna Souch
Design: Miles Hitchen
Illustration Manager: Brett MacNaughton
Marketing Manager: Michele Milano
Preface
This 12th edition celebrates the 66th year of Practical Haematology, a notable achievement. The first edition by JV (later Professor Sir John) Dacie was published in 1950. This work, and subsequent editions with Mitchell Lewis as co-author, were based on the haematology course for the University of London Diploma of Clinical Pathology and subsequently the MSc in Haematology at the then Royal Postgraduate Medical School.
In the last 66 years the techniques and instrumentation available to the laboratory haematologist have expanded at a rate once undreamed of. What has not changed is that laboratory haematology continues to provide the bedrock that supports the equally astonishing developments in clinical haematology. Haematology as a discipline remains strongest when it is an integrated discipline with a very close relationship between the laboratory and the clinical service. Reflecting this ideal state, the authors of this edition include laboratory scientists and clinical and laboratory haematologists.
The 12th edition, like its predecessors, incorporates the latest advances in laboratory haematology while continuing to describe traditional techniques that remain applicable, particularly, but not only, in under-resourced laboratories in low- and middle-income countries.
It is with sadness that we record the death of one of the authors, Ms Carol Briggs, BSc FIBMS, during the preparation of this edition.
We are honoured to have taken over the editorship of Practical Haematology from our distinguished predecessors, Sir John Dacie and Dr Mitchell Lewis. We hope that our efforts have done them justice.
Barbara J. Bain
Michael A. Laffan
Imelda Bates
Sir John V. Dacie, MD, FRCPath, FRS (1912–2005). S. Mitchell Lewis, BSc, MD, DCP(London), FRCPath, FIBMS (b 1924).
Megan Rowley, FRCP, FRCPath
Consultant in Haematology and Transfusion Medicine
St. Mary’s Hospital
Imperial College Healthcare NHS Trust London, UK
Jecko Thachil, MRCP, FRCPath
Consultant Haematologist
Haematology Department
Manchester Royal Infirmary Manchester, UK
Sarmad Toma, MBChB, MSc
Clinical Scientist
Cellular and Molecular Pathology
Imperial College Healthcare NHS Trust Hammersmith Hospital London, UK
Barbara J. Wild, PhD, FIBMS
Haemoglobinopathy Specialist Consultant
UK NEQAS Haematology and Transfusion
West Hertfordshire Hospitals NHS Trust Watford, UK
Nay Win, MB BS, FRCP, FRCPath, CTM(Edin)
Consultant Haematologist
Red Cell Immunohaematology
NHS Blood and Transplant (Tooting) London, UK
Mark Worwood, PhD, FRCPath, FMedSci
Emeritus Professor
Cardiff University School of Medicine Cardiff, UK
Gentle pressure should be applied to the swab with the arm slightly elevated for a minute before checking that bleeding has completely ceased. Finally, the puncture site should be covered with a small adhesive dressing.
Obtaining blood from an indwelling line or catheter is an important potential source of error. It is common practice to flush indwelling lines with heparin, so they must be flushed free from heparin and the first 5 ml of blood must be discarded before any blood is collected for laboratory testing. If intravenous fluids are being transfused into an arm, blood should generally not be collected from that arm; however, if this is essential, the specimen should be obtained from below the intravenous infusion with the tourniquet being placed below the site of infusion.
Postphlebotomy procedure
It is essential that every specimen is labelled with adequate patient identification immediately after the samples have been obtained and at the patient’s bedside. The information should include, as a minimum, surname and forename or initials, hospital number or other unique identifying number, date of birth and date and time of specimen collection. Many centres have adopted automated patient identification using a bar code printed on a wrist or ankle band worn by the patient. If this type of system is used both the specimen label and the request form should be barcoded with identical data, unless the sample is to be used for blood transfusion tests, in which case the label should be handwritten (see Chapter 22).
Specimens should be sent in individual plastic bags separated from the request forms to prevent contamination of the forms in the event of leakage. Samples and form should remain together until the request is registered in the laboratory reception area.
CAPILLARY BLOOD
Collection of capillary blood
Skin puncture is carried out with a needle or lancet. In adults and older children, blood can be obtained from a finger; the recommended site is the distal digit of the third or fourth finger on its palmar surface, lateral to the nail bed. In infants, satisfactory samples can be obtained by a deep puncture of the plantar surface of the heel in the area shown in Figure 1-1. The central plantar area and the posterior curvature should not be punctured in small infants, especially newborns, to avoid the risk of injury and possible infection to the underlying tarsal bones.
The area selected for capillary puncture should be cleaned with an antiseptic and allowed to dry. The skin is punctured to a depth of 2–3 mm with a sterile, disposable lancet. After wiping away the first drop of blood with dry sterile gauze the finger (or heel in infants) is squeezed gently to encourage a free flow of blood for collection. Free
Skin puncture in infants. Puncture must be restricted to the outer medial and lateral portions of the plantar surface of the foot indicated by the shaded area.
flow of blood is essential and only very gentle squeezing is permissible; ideally, large drops of blood should exude slowly but spontaneously.
After use, lancets should be placed in a puncture-resistant container for subsequent waste disposal. They must never be re-used on another individual.
BLOOD FILM PREPARATION
Ideally, blood films should be made immediately after the blood has been collected. However, in practice, blood samples are usually sent to the laboratory after a variable delay. Automated methods for making films are available and often employed in large centres. When films are not made on site they should be made in the laboratory soon after arrival as blood film morphology will deteriorate with any delay beyond a few hours.
DIFFERENCES BETWEEN CAPILLARY AND VENOUS BLOOD
Venous blood and capillary blood are not equivalent. Blood from a skin puncture is a mixture of blood from arterioles, veins and capillaries and it contains some interstitial and intracellular fluid.7 The packed cell volume/ haematocrit (PCV/Hct), red blood cell count (RBC) and
FIGURE 1-1
FIGURE 1-2 Effect of storage on blood cell morphology. Photomicrographs from films made from ethylenediaminetetra-acetic acid (EDTA) blood after 24 h at 20 °C. (A, B) Polymorphonuclear neutrophils; (C, D) monocytes; (E, F) lymphocytes. Red cell crenation is prominent in all images.
FIGURE 1-3 Morphological features of apoptosis.
importance of making films as soon as possible after the blood has been collected.
These artefactual changes must be distinguished from apoptosis, which can be seen in high-grade haematological neoplasms. Apoptosis is characterised, morphologically (Fig. 1-3), by cell shrinkage, a homogeneously glassy appearance of the nucleus, cytoplasmic condensation around the nuclear membrane and indentations in the nucleus, followed by its fragmentation. Apoptotic neutrophils with a single apoptotic body may be confused with nucleated red cells if the cytoplasmic features are not appreciated.
ACKNOWLEDGEMENT
The author wishes to acknowledge the contribution of previous authors of this chapter – the late Corrine Jury, Yutaka Nagai and the late Noriyuki Tatsumi – and of Gareth Ellis, who reviewed the content of this chapter.
REFERENCES
1. Advisory Committee on Dangerous Pathogens. Management of Hazard Group 4 viral haemorrhagic fevers and similar human infectious diseases of high consequence. Health and Safety Executive; November 2014. Available at www.gov.uk/government/uploads/system/ uploads/attachment_data/file/377143/VHF_guidance_document_ updated_19112014.pdf [accessed May 2016].
2. Tatsumi N, Miwa S, Lewis SM, International Council for Standardization in Haematology/ International Society of Hematology. Specimen collection, storage, and transportation to the laboratory for hematological tests. Int J Hematol 2002;75:261–8.
3. CLSI. Procedures for the collection of diagnostic blood specimens by venipuncture. Approved standard. 6th ed. Wayne, PA: CLSI; 2007. Document H3-A6.
4. NCCLS. Tubes and additives for venous blood specimen collection. Approved standard. 5th ed. Wayne, PA: NCCLS; 2003.
5. Tatsumi N, van Assendelft OW, Naka K. ICSH recommendation for blood specimen collection for hematological analysis. Lab Hematol 2002;8:1–6.
6. Saleem S, Mani V, Chadwick M, et al. A prospective study of causes of haemolysis during venepuncture: tourniquet time should be kept to a minimum. Ann Clin Biochem 2009;46:244–6.
7. Yang Z-W, Yang S-H, Chen L, et al. Comparison of blood counts in venous, finger tip and arterial blood and their measurement variation. Clin Lab Haematol 2001;23:155–9.
8. Zini G. Stability of complete blood count parameters with storage: toward defined specifications for different diagnostic applications. Int J Lab Hematol 2014;36:111–3.
alcoholic drink.4 An alternative approach is that, unless a test is usually done on a fasting patient, specimens are collected throughout the day on subjects who are not fasting or resting, as this will produce a reference range that is more relevant to results from patients. It is sometimes appropriate that the reference population is defined as having normal results for specific laboratory tests. For example, if determining a reference range for blood count components it may be necessary, in some populations, to exclude iron deficiency, β thalassaemia heterozygosity and, when relevant, α thalassaemia.
STATISTICAL PROCEDURES
In biological measurements, it is usually assumed that the data will fit a specified type of pattern, either symmetric (Gaussian) or asymmetric with a skewed distribution (non-Gaussian). With a Gaussian distribution, the arithmetic mean (x) can be obtained by dividing the sum of all measurements by the number of observations. The mode is the value that occurs most frequently and the median (m) is the point at which there are an equal number of observations above and below it. In a true Gaussian distribution they should all be the same. The standard deviation (SD) can be calculated as described on page 565. If the data fit a Gaussian distribution, when plotted as a frequency histogram the pattern shown in Figure 2-1 is obtained. Taking the mode and the calculated SD as reference points, a Gaussian curve is superimposed on the histogram. From this curve, practical reference limits can be determined even if the original histogram included outlying results from some subjects not belonging to the
normal population. Limits representing the 95% reference range are calculated from the arithmetic mean ±2SD (or more accurately ±1.96SD).
When there is a log normal (skewed) distribution of measurements, the range to 2SD may even extend to zero (Fig. 2-2, A). To avoid this anomaly, the data should be plotted on semilogarithmic graph paper to obtain a normal distribution histogram (Fig. 2-2, B). To calculate the mean and SD the data should be converted to their logarithms. The log–mean value is obtained by adding the logs of all the measurements and dividing by the number of observations. The log SD is calculated by the formula on page 566 and the results are then converted to their antilogs to express the data in the arithmetic scale. This process is now generally carried out using an appropriate statistical computer program.
When it is not possible to make an assumption about the type of distribution, a nonparametric procedure may be used instead to obtain the median and SD. To obtain an approximation of the SD, the range that comprises the middle 50% spread (i.e. between 25 and 75% of results) is read and divided by 1.35. This represents 1SD.
Confidence limits
In any of the methods of analysis, a reasonably reliable estimate can be obtained with 40 values, although a larger number (≥120) is preferable (Fig. 2-3).5 When a large set of reference values is unattainable and precise estimation is impossible, a smaller number of values may still serve as a useful clinical guide. Confidence limits define the reliability (e.g. 95% or 99%) of the established reference values
Number of subjects
FIGURE 2-1 Example of establishing a reference range. Histogram of data of Hb measurements in a population, with Gaussian curve superimposed. The ordinate shows the number that occurred at each reference point. The mean was 140 g/l; the reference ranges at 1SD, 2SD and 3SD are indicated.
HAEMATOLOGICAL VALUES FOR NORMAL INFANTS (AMALGAMATION OF DATA DERIVED FROM VARIOUS SOURCES; EXPRESSED AS MEAN ± 2SD OR 95% RANGE)*
(RBC) (×1012/l)
Mean cell haemoglobin concentration (MCHC) (g/l)
Reticulocyte count (×109/l)
Lymphocyte subsets (×109/l)†
Platelets
*There have been some reports of WBC and platelet counts being lower in venous blood than in capillary blood samples.
† Approximations because wide variations have been reported in different studies.
ferritin, possibly associated with loss of iron in sweat. Conversely, in sprinters who require a short burst of very strenuous muscular activity, there is a transient increase in RBC by 0.5 × 1012/l and in Hb by 15 g/l, largely because of a reduction in plasma volume and to a lesser extent the re-entry into the circulation of cells previously sequestered in the spleen. The effects of exercise must be distinguished from a form of haemolysis known as ‘runner’s anaemia’ or ‘march haemoglobinuria’, which occurs as a result of pounding of the feet on the ground.16 A similar phenomenon has been reported in djembe drummers from repeated hand trauma.
Posture
There is a small but significant alteration in the plasma volume with an increase in Hb and Hct as the posture changes from lying to sitting, especially in women;17 conversely, changing from walking to lying results in a 5–10% decrease in the Hb and Hct. The difference in position of the arm during venous sampling, whether dependent or held at atrial level, can also affect the Hct.
These aspects highlight the relevance of using a standardised method for blood collection, although this is not necessarily practicable in routine practice. This is discussed in Chapter 1 and the differences between venous and capillary blood are described on page 3.
Diurnal and seasonal variation
Changes in Hb and RBC during the course of the day are usually slight, about 3%, with negligible changes in the MCV and MCH. However, variation of 20% occurs with reticulocyte counts.18 Studies of diurnal variation of serum erythropoietin have shown conflicting results. Pronounced, but variable, diurnal variations are seen in serum iron and ferritin and in patients taking iron-containing supplements.19 It has been suggested that minor seasonal variations also occur, but the evidence for this is conflicting.
Altitude
The effect of altitude is to reduce the plasma volume, increase the Hb and Hct and raise the number of circulating red cells with a lower MCV.20 The magnitude of the polycythaemia depends on the degree of hypoxaemia. At an altitude of 2000 m, Hb is ≈ 8–10 g/l and Hct is 0.025 higher than at sea level; at 3000 m, Hb is ≈ 20 g/l and Hct is 0.060 higher; and at 4000 m, Hb is 35 g/l and Hct is 0.110 higher. Corresponding increases occur at intermediate and at higher altitudes.20 These increases appear to be the result of enhanced erythropoiesis secondary to the hypoxic stimulus, and the decrease in plasma volume that occurs at high altitudes.
Smoking
Cigarette smoking affects Hb, RBC, Hct and MCV (see p. 16).
Leucocyte count
At birth, the total leucocyte count is high; neutrophils predominate, reaching a peak of ≈ 13.0 × 109/l within 6–8 h for neonates of >28 weeks’ gestation and 24 h for those delivered at <28 weeks.9 The count then falls to ≈ 4.0 × 109/l over the next few weeks and then stabilises (Tables 2-1, 2-2 and 2-3). The lymphocytes decrease during the first 3 days of life, often to a low level of ≈ 2.0–2.5 × 109/l, and then rise up to the tenth day; after this time, they are the predominant cell (up to about 60%) until the fifth to seventh year, when neutrophils predominate. From that age onwards, the levels are the same as those of adults. There are also slight sex differences; the total leucocyte count (WBC) and the neutrophil count may be slightly higher in girls than in boys, and in women than in men.21 After the menopause, the counts fall in women so that they tend to become lower than in men of similar age.
People differ considerably in their leucocyte counts. Some tend to maintain a relatively constant level over long periods; others have counts that may vary by as much as 100% at different times. In some subjects, there appears to be a rhythm, occurring in cycles of 14–28 days, and in women this may be related to the menstrual cycle or to the use of oral contraception. There is no clear-cut diurnal variation, but minimum counts are found in the morning with the subject at rest and during the course of a day there may be differences of 14% for the WBC, 10% for neutrophils, 14% for lymphocytes and 20% for eosinophils;18 in some cases this may result in a reversed neutrophil:lymphocyte ratio. Random activity may raise the count slightly; strenuous exercise causes increases of up to 30 × 109/l, partly because of mobilization of marginated neutrophils and changes in cortisol levels.22 Large numbers of lymphocytes and monocytes also enter the bloodstream during strenuous exercise. However, there have also been reports of neutropenia and lymphopenia in athletes undergoing strenuous exercise.23
Epinephrine (adrenaline) injection causes an increase in the numbers of all types of leucocytes (and platelets), possibly reflecting the extent of the reservoir of mature blood cells present not only in the bone marrow and spleen but also in other tissues and organs of the body. Emotion may possibly cause an increase in the leucocyte count in a similar way. A transient lymphocytosis with a reversed neutrophil:lymphocyte ratio occurs in adults with physical stress or trauma. The effect of ingestion of food is uncertain. Cigarette smoking has an effect on the leucocyte count (see p. 16).
A moderate increase in the WBC, of up to 15 × 109/l, is common during pregnancy, owing to an increase in the neutrophil count, with the peak in the second trimester. The count returns to non-pregnancy levels about a week after delivery.24
3 Basic Haematological Techniques
Carol Briggs • Barbara J. Bain
CHAPTER OUTLINE
Haemoglobinometry, 19
Measurement of haemoglobin concentration using a spectrometer (spectrophotometer) or photoelectric colorimeter, 19
Haemiglobincyanide (cyanmethaemoglobin) method, 20
Diluent, 20
Haemiglobincyanide reference standard, 20 Method, 21
Calculation of haemoglobin concentration, 21
Direct spectrometry, 22
Direct reading portable haemoglobinometers, 22
Colour comparators, 22
Portable haemoglobinometers, 22
Noninvasive screening tests, 23
Range of haemoglobin concentration in health, 23
Packed cell volume or microhaematocrit, 23
International Council for Standardisation in Haematology reference method, 24
Surrogate reference method, 24
Range of packed cell volume in health, 24
Manual cell counts and red cell indices, 24
Range of MCHC in health, 25
Manual differential leucocyte count, 25 Method, 25
Basophil and eosinophil counts, 26
Range of eosinophil count in health, 26
Range of basophil count in health, 26
Reporting the differential leucocyte count, 26
Reference differential white cell count, 27
Range of differential white cells in health, 27
Platelet count, 27
Range of platelet count in health, 27
Reticulocyte count, 27
Reticulocyte stains and count, 27
Fluorescence methods for performing a reticulocyte count, 30
Manual reference method, 30
Range of reticulocyte count in health, 30
Automated blood count techniques, 30
Haemoglobin concentration, 31
Red blood cell count, 31
Counting systems, 31
Impedance counting, 31
Light scattering, 32
Reliability of electronic counters, 32
Setting discrimination thresholds, 33
Packed cell volume and mean cell volume, 33
Red cell indices, 35
Mean cell volume, 35
Mean cell haemoglobin and mean cell haemoglobin concentration, 35
Variations in red cell volumes: red cell distribution width, 35
Percentage hypochromic red cells and variation in red cell haemoglobinisation: haemoglobin distribution width, 36
White blood cell count, 36
Automated differential count, 37
The automated immature granulocyte count, 38
The automated nucleated red blood cell count, 38